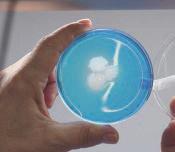
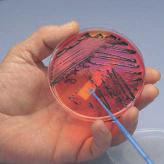

herkauwer





































geïnactiveerd vaccin in injecteerbare emulsie voor runderen. lyofilisaat en oplosmiddel voor suspensie voor injectie of neusspray voor runderen SAMENSTELLING PER DOSIS (2ml): HSL: Mannheimia haemolytica biotype A serotype A1, geïnactiveerde celvrije suspensie met leukotoxoïd ELISA > 2,8 (*) en geïnactiveerde Histophilus somni Bailie-stam MAT > 3,3. Nasym: Elke dosis van 2 ml bevat: Lyofilisaat: Levend verzwakt bovine respiratoir syncytieel virus (BRSV), stam Lym-56…. 104.7-6.5 CCID50 Oplosmiddel: Fosfaatgebufferde oplossing INDICATIES: HSL: Voor de vermindering van klinische verschijnselen en longlaesies veroorzaakt door Mannheimia haemolytica serotype A1 en Histophilus somni bij kalveren vanaf 2 maanden oud Nasym: Actieve immunisatie van rundvee om de verspreiding van het virus en de respiratoire klinische symptomen die worden veroorzaakt door een bovine respiratoire syncytiële virusinfectie, te verlagen TOEDIENINGSWEG: HSL: voor subcutaan gebruik Nasym: voor intranasaal of intramusculair gebruik DOSERING: HSL: 2 ml/kalf van 2 maanden oud. Deze dosis van 2 ml moet na 21 dagen worden herhaald. Vaccineer kalveren via een subcutane injectie in het prescapulaire gebied. Toediening van de dosis aan afwisselende zijden heeft de voorkeur. Nasym: Reconstitueer het vaccin met de overeenkomstige hoeveelheid oplosmiddel. De volgende doses en toedieningswijze dienen te worden gebruikt: Rundvee vanaf 9 dagen leeftijd: Primaire vaccinatie (intranasaal gebruik): Verstuif 1 ml in elk neusgat (zodat het totale toegediende volume 2 ml bedraagt). Hervaccinatie: 2 maanden na de primaire vaccinatie één intramusculaire injectie van 2 ml toedienen en vervolgens om de 6 maanden middels intramusculaire injectie hervaccineren. Rundvee vanaf 10 weken leeftijd: Primaire vaccinatie (intramusculaire injectie): Eén intramusculaire injectie van 2 ml, gevolgd door een tweede intramusculaire injectie van 2 ml 4 weken later. Hervaccinatie: Dien 6 maanden na voltooiing van het primaire vaccinatieschema één intramusculaire injectie van 2 ml toe en vervolgens elke 6 maanden na de laatste hervaccinatie.


BIJWERKINGEN: HSL: Na elke vaccinatie kan er gedurende 4 dagen een temperatuurverhoging (tot 2°C) optreden alsook een lokale zwelling van 1 tot 7 cm. Deze zwelling kan 14 dagen na de vaccinatie verdwenen of duidelijk in omvang afgenomen zijn, maar in sommige gevallen na de tweede toediening tot wel 4 weken aanhouden. Nasym: Na vaccinatie kan er vaak een lichte verandering in de fecale consistentie worden waargenomen. CONTRA-INDICATIES: Vaccineer geen zieke dieren en vaccineer niet bij een overgevoeligheid voor de actieve bestanddelen, het adjuvans of hulpstoffen WACHTTIJD: nul dagen. SPECIALE VOORZORGSMAATREGELEN: alleen gezonde dieren mogen gevaccineerd worden. Laat het vaccin voordat het wordt toegediend op een temperatuur van +15 tot +25°C komen. Schudden voor gebruik. Dit product bevat minerale olie. Onbedoelde injectie/zelfinjectie kan pijn en zwelling veroorzaken, vooral als de injectie in een gewricht of vinger plaatsvindt. In zeldzame gevallen kan dit leiden tot verlies van de aangetaste vinger als er niet onmiddellijk medische hulp wordt verleend. Gekoeld bewaren en transporteren 2 °C - 8 °C. Niet in de vriezer bewaren. Bescherm tegen licht. Nasym oplosmiddel: Bewaren onder 25 °C. Uitsluitend voor diergeneeskundig gebruik. Buiten het zicht en bereik van kinderen bewaren. VERPAKKINGSGROOTTEN: HSL: 10 doses per flacon (20 ml) en 50 doses per fles (100 ml). Nasym: 1 dosis + 2 ml oplosmiddel, 5 dosissen + 10 ml oplosmiddel, 25 dosissen + 50 ml oplosmiddel. REGISTRATIENUMMER: HSL: REG NL 104600 UDD Nasym: EU/2/19/241/001-005 UDD VERGUNNINGHOUDER:
wijze. Voor verdere
verwijzen wij u naar de bijsluiter
HIPRA BENELUX N.V. Nieuwewandeling 62, 9000 Gent, Belgium Tel. +32 (0)9 296 44 64, benelux@hipra.com, www.hipra.com
Het zijn onzekere tijden, ook voor veehouders. Tijdens het schrijven van dit voorwoord is het rapport over de stikstofgesprekken net uitgebracht. Ik hoop dat het genoeg handvatten geeft om te kunnen werken aan de toekomst. En dat we de afgelopen roerige tijd, met veel onrust en polarisatie achter ons kunnen laten. Met een langetermijnaanpak die recht doet aan alle partijen, dan kunt u als klant weer verder. Wij dragen er graag aan bij met onze oplossingen op het gebied van diergezondheid, ook waar die raken aan milieu- en duurzaamheidsvraagstukken.
In deze editie van Herkauwer is er veel aandacht voor preventie. Het gaat om het voorkomen van ziekten, bewaken van gezondheid en behandelen waar nodig. Een gezonde opfok, alles voor een goede start, werkt de waterbehandelingsinstallatie naar behoren? Als dierenarts kwam je voorheen vrijwel altijd om pro-
blemen op te lossen. Nu denk en werk je mee om de diergezondheid en het management op het bedrijf verder te verbeteren.
En dit alles doen we zonder dat we stoppen met het signaleren van problemen, zoals Mortellaro of dieren die op de sectietafel zijn beland na drenchen of het gebruik van bijvoorbeeld een pillenschieter. Ook dit biedt kansen om te leren en te verbeteren. Altijd met als doel het verbeteren van diergezondheid en dierenwelzijn, waarbij dit ook ten gunste komt van duurzaamheid en ef ciëntie op het bedrijf.
En doordat iedereen blijft leren, zetten we zulke mooie stappen om de diergezondheid en het dierenwelzijn op een steeds hoger niveau te krijgen. Dit past bij de proactieve en op verbetering gerichte veehouders van nu.


Actueel
Kalender
Bereikbaarheid Royal GD is op werkdagen telefonisch bereikbaar van 07.30 tot 19.00 uur via 088 20 25 500.
Alle genoemde GD-tarieven in deze uitgave zijn exclusief btw en 9,95 euro basiskosten.
Ophaaldienst voor sectie- en monstermateriaal Aanmelden: via het aanmeldformulier op www.gddiergezondheid.nl of telefonisch 088 20 25 500 (24 uur per dag). Wij halen het materiaal dan zo spoedig mogelijk op. Sectie- en monstermateriaal kan worden gebracht van maandag tot en met vrijdag van 8.00 tot 17.00 uur.

Herkauwer is een uitgave van Royal GD Redactie Sietske Haarman, Linda van Duijn, Jet Mars, Marjolijn Waanders, Inge Nijhoving | Beeldredactie Wendy van de Streek | Eindredactie Jessica Fiks | Redactieadres Royal GD, Marketingsupport & Communicatie, Postbus 9, 7400 AA Deventer, T 088 20 25 500, redactie@gddiergezondheid.nl, www.gddiergezondheid.nl | Productiecoördinatie Senefelder Misset Doetinchem B.V. | Basisontwerp Studio Kaap | Vormgeving Dock35 Media B.V. | Druk Senefelder Misset Doetinchem B.V. | Abonnementen Herkauwer wordt gratis toegezonden aan relaties van Royal GD. Een jaarabonnement (drie nummers) voor personen buiten de doelgroep kost 19,20 euro (exclusief btw) | Advertenties Dock35 Media B.V., T. 0314 - 35 58 52 | Verschijningsfrequentie drie keer per jaar | Suggesties Suggesties voor dit blad kunnen worden doorgegeven via redactie@gddiergezondheid.nl Overname van artikelen is toegestaan uitsluitend na toestemming van de uitgever. | Disclaimer Royal GD en de redactie zijn niet verantwoordelijk en daardoor niet aansprakelijk voor de inhoud van de geplaatste advertenties en advertorials.
ISSN: 1875a-2594



Dit blad niet meer ontvangen of een adreswijziging doorgeven? Dat kan via 088 20 25 500. Vraag naar klantdatabeheer, of stuur een e-mail naar brbs@gddiergezondheid.nl.
Klauwgezondheid: hoe pak je Mortellaro aan?
Een handig schema als hulp bij de jongvee-aanpak
Reportage: het belang van een goede start
VeeOnline: zo zit het met oorbiopten
Drinkwater: werkt de waterbehandelingsinstallatie naar behoren?

Kom langs tijdens de RMV
Monitoring: het gebruik van drenchslangen
Uit het lab: de onderzoeken op
inzichtelijk maken
Relatiebeheer
getal
volgens
Een kwart van de kalveren krijgt te maken met M. haemolytica. Veel runderen dragen deze bacterie bij zich zonder dat het problemen oplevert, maar het kan ook leiden tot ernstig zieke runderen en zelfs acute sterfte. Het is dan ook van belang om een infectie vroegtijdig te signaleren. Onze nieuwe Mannheimia haemolytica-antistoffentest maakt het mogelijk om naast volwassen rundere n ook voor kalveren zicht te krijgen op recente infecties met M. haemolytica. Heeft u hoestende kalveren? Uw dierenarts kan dit serumonderzoek nu bij ons aanvragen.
Altijd op de hoogte zijn van het laatste GD-nieuws? Dan kun je je aanmelden voor onze nieuwsbrieven en kiezen voor de diersoort(en) waarover je meer informatie wilt ontvangen. Zo versturen we maandelijks de Actueel Rund, met het laatste diergezondheidsnieuws en de laatste ontwikkeling op het gebied van diergezondheid.
AANMELDEN VOOR DE NIEUWSBRIEFDe diergezondheid en productie vraagt om een gebalanceerde mineralen- en vitaminevoorziening. De behoefte is sterk afhankelijk van diverse factoren, zoals lactatiestadium en productieniveau. Ook de onderlinge interacties tussen mineralen beïnvloeden de opname door dieren. Denk daarbij aan de hogere absorptie van koper bij een laag gehalte aan molybdeen en zwavel in het rantsoen. Controle van de mineralenvoorziening op koppelniveau in tankmelk is mogelijk met de Mineralencheck. Een meer gerichte controle bij een bepaalde groep of problemen kan met bloed- of leverbioptenonderzoek worden uitgevoerd.
Iedere veehouder wil een gezonde veestapel. Gezonde koeien geven makkelijker meer melk en er is minder vervanging nodig. Dit leidt tot lagere kosten voor opfok, arbeid, mest en voer. Waar dieren worden gehouden, komen ook wel eens gezondheidsproblemen voor. Snel ingrijpen is dan noodzakelijk. Welke aanpak werkt het beste?

Laagdrempelig kennismaken met één van onze tankmelkprogramma’s Tankmelkonderzoek helpt om afwijkingen vroegtijdig te signaleren en inzichtelijk te maken waar het nog beter kan. Dit najaar bieden we een voordelige kennismaking met onze programma’s. Nieuwe deelnemers ontvangen het eerste kwartaal dat ze deelnemen namelijk 33 procent korting.
Kijk voor meer informatie en deelnemende programma’s in de bijlage bij deze Herkauwer of scan de QR-code.
Bronwater dat wordt gebruikt om de melkwinningsapparatuur te reinigen of de melk voor te koelen, hoort te voldoen aan bepaalde normen. Wij kunnen dit water onderzoeken op de door KKM of Foqus planet gestelde normen voor waterkwaliteit én we regelen dat het monster elk jaar tijdig wordt genomen. Hiervoor werken we samen met getrainde, erkende watermonsternemers van CRV.


Het Pakket Spoorelementen geeft via bloedonderzoek inzicht in de actuele opname van de belangrijkste spoorelementen voor rundvee: selenium, koper, zink en jodium. Op de uitslag staan de referentiewaarden voor volwassen dieren en sinds kort ook voor kalveren en pinken. Je ziet welke variatie in de concentratie van een spoorelement verwacht mag worden bij dieren van elke speci eke groep. Zo is één oogopslag duidelijk of de voorziening aansluit bij de behoefte of dat bijsturen in de mineralengift nodig is.
Wist je dat je ons ook kunt volgen op Facebook en Instagram? Op die kanalen staan inzichten op het gebied van diergezondheid, verhalen, interviews, tips en quizzen. Volg ons ook en blijf zo op de hoogte!


Bij rundvee is een leverbotinfectie vaak sluimerend aanwezig en kan zich uiten in verminderde vruchtbaarheid, slechtere groei en weerstandsvermindering. Na opname van besmettelijke cysten via gras trekt de jonge leverbot vanuit de darmen richting lever. De volwassen bot is ongeveer twee tot vier centimeter lang, leeft in de galgangen van de lever en produceert hier veel eieren die via de gal met de mest worden uitgescheiden. Voor de verdere ontwikkeling van eieren tot leverbot is de leverbotslak nodig als tussengastheer. Deze slak leeft op plaatsen waar de bodem het grootste deel van het jaar vochtig is, zoals in greppels, slenken, vertrapte slootkanten en kwelplaatsen achter dijken. Zonder tussengastheer komt leverbotziekte niet voor.

De leidraad leverbot bevat informatie over leverbot, diagnostiek, preventieve maatregelen en behandelmogelijkheden.
Met sterke klauwen loopt alles lekkerder. Het is de basis voor actieve, productieve koeien met een lange levensduur. Actieve koeien vreten beter, geven meer melk en zijn gemakkelijker drachtig te krijgen. En ze gaan langer mee. Gezonde, sterke klauwen zijn een belangrijke voorwaarde voor langer probleemloos melken.
Gezond oud worden met sterke klauwen
SCAN DE QR-CODE VOOR MEER INFORMATIEBEZOEK DE WEBPAGINA BEZOEK ONZE SPECIALE WEBPAGINA’S OVER KLAUWEN




















Ieder najaar is het een terugkerend moment op veel Nederlandse melkveebedrijven, het jongvee wordt weer naar de stal gehaald. Nu hebben niet alleen worminfecties invloed op een verminderde conditie of een achterblijvende groei. Ook een tekort aan mineralen kan als gevolg hebben dat het jongvee onvoldoende ontwikkelt. Bekend is dat op veen- en zandgronden deze risico’s groter zijn, maar doordat gras de laatste jaren steeds langer beschikbaar is loopt het jongvee vaak langer buiten. Hierdoor kan een tekort makkelijker optreden.


Check daarom bij het op stal gaan van het jongvee de actuele status van de belangrijkste mineralen voor runderen door van vier tot zes dieren bloedonderzoek te doen. Bij een tekort kan worden bijgestuurd en tevens kunnen de resultaten meegenomen worden naar het komende weideseizoen om nog meer naar behoefte te voeren.
Om problemen met maagdarmwormen bij volwassen koeien te voorkomen, is het gewenst dat jongvee hier al weerstand tegen opbouwt. Het is de bedoeling dat de kalveren deze weerstand tegen maagdarmwormen na afloop van het eerste weideseizoen hebben opgedaan, met zo min mogelijk schade door deze besmetting.
Vaak is het op het oog niet duidelijk of en in hoeverre er een besmetting heeft plaatsgevonden. Bij het opstallen komt dan vaak de vraag weer op of het nodig is de dieren te behandelen.
Bloedonderzoek naar het pepsinogeengehalte bij kalveren geeft inzicht in welke mate een dier op dat moment (nog) schade ondervindt van maagdarmwormlarven en daarmee of behandeling zinvol en nodig is. Bij gepoold bloedonderzoek laat u van vijf dieren uit dezelfde diergroep bloed tappen. De uitslag helpt u om, in overleg met uw dierenarts, te bepalen of een opstalbehandeling nodig is.
Pepsinogeenonderzoek is zinvol tot uiterlijk een week na het opstallen.
SCAN DE QR-CODE VOOR MEER INFORMATIEWanneer Mortellaro voorkomt op het bedrijf is er een grote kans dat de dieren als vaars besmet zijn geraakt. Toch komt het ook regelmatig voor dat ook het jongvee al besmet is door het gemeenschappelijk huisvesten (drachtige pinken met droge koeien), via de mestschuif of via besmette laarzen. Als dieren als pink Mortellaro hebben gehad is de kans dat ze het als vaars opnieuw krijgt zes keer zo groot. Bovendien produceren ze minder melk en laten hun tochtigheid minder zien. Komt Mortellaro al bij het jongvee voor? Voorkom dan overbezetting, zorg voor schone roosters en gebruik aparte laarzen in de jongveestal of spoel deze af en ontsmet ze voor u bij het jongvee op de roosters komt, bijvoorbeeld met een ontsmettingsmat of rugspuit met klauwdesinfectans. Zorg voor een goede mineralenvoorziening voor een betere weerstand van de huid. En spuit regelmatig (één tot twee keer per week) de onderpoten af, onder de bijklauwtjes met de rugspuit.
Mortellaro is de belangrijkste infectieuze klauwaandoening in de melkveehouderij in West-Europa. De aanpak ervan is gericht op de behandeling van het probleem op dierniveau en het voorkomen van nieuwe infecties op bedrijfsniveau. Wat kun je doen om deze klauwaandoening in de kiem te smoren?
Doel van de aanpak van het probleem op dierniveau is het wegnemen van de klinische verschijnselen. Dat houdt in dat de aan-
gedane huid volledig hersteld is, de letsels niet meer pijnlijk en de dieren niet meer kreupel zijn en het dierenwelzijn geborgd is. Het negatieve effect op de melkproductie en voortplanting blijft hierdoor beperkt. En je vermindert met de aanpak op dierniveau ook de infectiedruk binnen de koppel.

De aanpak op dierniveau bestaat uit het behandelen van alle aanwezige letsels van Mortellaro; de actieve (M1- en M2-score in Digiklauw) én de chronische (M4-score in Digiklauw). De M2-letsels hebben het grootste effect op de kliniek en productie. Een koppelbehandeling heeft het grootste effect op de infectiedruk. Dit omdat Mortellaro zich binnen een koppel gedraagt zoals een infectieziekte.
Vergeet jongvee en droge koeien niet Indien koppelbehandeling niet mogelijk is, raden we aan om dieren te behandelen bij kreupelheid en bij de momenten van preventief bekappen, zijnde het droogzetten en na de piek van de lactatie of bij het koppelbekappen. Vergeet niet om alle groepen waar Mortellaro voorkomt, ook jongvee en droge koeien, mee te nemen. GD-onderzoek toont aan dat dieren die als pink Mortellaro hebben doorgemaakt, de kans dat het zich bij deze melkvaarzen opnieuw openbaart zes maal groter is dan bij dieren die vrij zijn gebleven van Mortellaro. Om de eerste besmetting bij jongvee te voorkomen, is het aan te raden om schone laarzen aan te trekken voordat je de jongveehuisvesting betreedt.
Naast de typische plaats op de achterpoten aan de achterkant van de tussenklauwspleet, kunnen letsels ook voorkomen bij de bijklauwen, de voorkant van de poten en aan de voorpoten. Ook
hebben dieren met een tyloom vaak ook Mortellaro-letsel op het tyloom. In dit geval bevelen we een operatieve verwijdering van het tyloom door de dierenarts aan.
Het behandelen van de individuele letsels bestaat uit volgende stappen:
1. Wondtoilet: zorg ervoor dat het letsel en de omgeving ervan schoon is door het te wassen met water. Dep vervolgens het letsel droog met een schone doek en probeer te vermijden dat het letsel gaat bloeden.
2. Product aanbrengen: gebruik bij voorkeur een product dat geregistreerd is voor de behandeling van Mortellaro, zonder antibioticum en waarvoor de werkzaamheid door onafhankelijk wetenschappelijk onderzoek is aangetoond. De dierenarts kan hierin adviseren.
3. Verband: gebruik een gaasje tussen het product en de polstering/watten of het elastisch verband. Het verband kan 3 tot 7 dagen blijven zitten, afhankelijk van de hygiëne op het bedrijf. We raden aan om verbanden met een felle kleur te gebruiken. Dit maakt het opvolgen van poten met een verband makkelijker, waardoor letsels ten gevolge van het verband worden vermeden.

4. Pijnstilling: het gebruik een pijnstiller (NSAID) geeft een hogere kans op het eerder eindigen van de kreupelheid en
Voor de aanpak van Mortellaro zijn ook goede ligboxen en een goed ligbed van belang. Op een rustmoment moet meer dan 85 procent van de koeien in de ligbox ook echt liggen.
heeft een gunstig effect op de melkproductie van kreupele dieren met Mortellaro.
5. Herhaling: het advies is om de lokale behandeling te herhalen tot de huid volledig is genezen. Bij onvoldoende herstel na drie behandelingen is het wenselijk de dierenarts naar de letsels te laten kijken.
Om nieuwe letsels in de koppel te voorkomen adviseren we om het koecomfort te optimaliseren. Hierdoor staan de koeien minder op de roosters, waardoor minder kans is op besmetting. Daarnaast is het wenselijk om de hygiëne te optimaliseren, met name van de roostervloer. Overweeg om de stalvloer één of twee keer per jaar te ontsmetten. Regelmatig gebruik van een voetbad, rugspuit of mat om de klauwen te ontsmetten is een belangrijke factor om Mortellaro op het bedrijf onder controle te houden. Het gebruik van een voetbad, rugspuit of mat wordt afgeraden bij dieren met actieve Mortellaro (M1- of M2-score in Digiklauw) of een verband.
Voor een structurele aanpak van de klauwgezondheid op het bedrijf hebben wij een handig e-book gemaakt.

Productinformatie Bovigen Scour, emulsie voor injectie voor runderen. Doeldier: Rund (drachtige koeien en vaarzen). Werkzame bestanddelen: Bovine rotavirus, stam TM-91, serotype G6P1 (geïnactiveerd), Bovine coronavirus stam C-197 (geïnactiveerd), Escherichia coli stam EC/17 (geïnactiveerd) met expressie van F5 (K99) adhesine. Indicaties: Voor de actieve immunisatie van drachtige koeien en vaarzen ter stimulering van antilichamen tegen E. coli adhesie F5 (K99) antigeen, rotavirus en coronavirus. Dosering: Eén dosis: 3 ml. Gedurende de dracht één dosering, tussen 12 en 3 weken voor de verwachte a alfdatum. Contra-indicaties: Geen. Wachttermijn: 0 dagen. Bijwerkingen: Een lichte zwelling van 5-7 cm in diameter op de injectieplaats komt vaak (1 tot 10 van de 100 dieren) voor en kan in sommige gevallen in de beginfase gepaard gaan met lokaal een verhoogde temperatuur. Deze lichte zwelling verdwijnt binnen 15 dagen. Waarschuwingen: vaccineer enkel gezonde dieren - zie bijsluiter. Registratienummer: REG NL 117300.






Kanalisatie: UDD. Distributeur: Virbac Nederland bv – Barneveld. Lees voor gebruik eerst de bijsluiter. Neem voor meer informatie over Bovigen® Scour of andere diergeneesmiddelen contact op met Virbac Nederland bv of kijk op www.cbg-meb.nl.
Vraag uw dierenarts om advies.

Breed spectrum vaccin ter preventie van kalverdiarree


“Aandacht, aandacht en nog eens aandacht.”Jessica Fiks, redacteur HET BELANG VAN JONGVEE-OPFOK
Kalveren zo probleemloos mogelijk laten opgroeien, dat is waar Kristy Kornegoor en haar man Martijn stevig op inzetten. Ze kiezen bewust voor een duurzame bedrijfsvoering voor hun koppel van ruim honderd melkkoeien. “Door de hogere levensduur is er weinig vervanging nodig en hoeven we dus minder jongvee aan te houden. Op dit moment hebben we er een stuk of veertig, verdeeld over alle leeftijdsgroepen. We doen de jongveeopfok zelf, puur voor ons eigen bedrijf. Het is dus extra belangrijk dat onze kalfjes gezond opgroeien tot hoogproductieve melkkoeien.”
De keuze voor minder jongvee betekent dat een goede jongveecy clus nodig is. Dat hebben ze goed onder de knie en Kristy ver zorgt de kalveren met veel plezier en passie. Terwijl we over het terrein lopen zie je hoe ze bezig is met precies werken en conti nue oog heeft voor de dieren. Dat is ook een van de sleutels van het succes. Kristy: “Ik zeg wel eens: aandacht, aandacht en nog eens aandacht. Dat is zo belangrijk, je kunt zoveel aflezen als je het dier bekijkt. Ligt een kalf te lang? Hoe komen ze op de melk af? Hoe drinken ze? Hoe is de mest? Door overal aandacht voor te hebben zie je eventuele problemen sneller en kun je ingrijpen.”
Het begint bij de afkalvende koeien: het droogstandsrantsoen is erg belangrijk, voor zowel koe als kalf. De droogstand is de basis voor makkelijk afkalven en een goede lactatie. Daarom zitten Kristy en Martijn er qua rantsoen dicht op. De kalveren worden geboren in de uitloopweide voor droge koeien, in de winter in een groot strohok met meerdere close-up koeien of het afkalfhok. “Dat is wel een aandachtspunt”, geeft Kristy toe. “De ondergrond is vast en kun je minder goed schoonhouden. Hij staat eigenlijk nooit langere tijd leeg en na elk kalf uitmesten en opnieuw instrooien is onpraktisch. We strooien wel vaak op. In de uitloop weide staan in verhouding met de gewone weide veel koeien op een kleiner oppervlak, waardoor de infectiedruk daar wat hoger is. Het kalf halen we daarom zo snel mogelijk weg en we leggen het in een schone eenlingbox. Wij melken de koeien na het afkalven direct uit. De spenen worden schoongemaakt en na het voorstra len wordt de koe met de schone minimelker of robot gemolken.”

Het kalf gaat zo snel mogelijk naar de eenlingbox, met daarin een goede laag stro. De biest gaat in emmers en in een fles. Ze geven in principe altijd de biest van de moeder en meten de brixwaarde. In de vriezer staat een voorraad met biest van een hoge kwaliteit. Ieder kalf heeft altijd een schone ‘biestverstrekker’ en ook daarna een schone, genummerde, speenemmer. “De eerste biest zit er bin nen een uur in”, geeft Kristy aan. “Die portie is 4 liter en na 8 tot 12 uur geven we nog een keer 2 liter. Zo krijgen de kalveren bin nen 24 uur 6 tot 8 liter biest binnen. Dat is belangrijk om een goede weerstand op te bouwen. We geven daarna drie voedingen per dag, dus ze krijgen dan ook in totaal zo’n zes tot acht liter melk per dag. Ze drinken het meteen op en daarna maak ik alles weer goed schoon.”


Kristy: “De eerste drie dagen krijgen kalveren biest, daarna koemelk van een gezonde koe, dus niet van een koe die antibiotica krijgt of een hoog celgetal heeft.” Na een week of drie gaan ze

over op poedermelk en nog een week later gaan de kalveren over naar een groepshok. Stierkalfjes krijgen twee weken lang koemelk. “Wij kiezen ervoor om de kalveren wat langer in de eenlingboxen te houden, omdat ze dan sterker en weerbaarder zijn. Als ze naar een groepshok gaan krijgen ze te maken met meer infectiedruk vanuit de omgeving. Zo’n hok is in onze bedrijfsvoering minder goed te reinigen”, legt Kristy uit.
Overgangen klein houden Kristy: “Elke verandering die de kalfjes meemaken zorgt voor stress. Dus wij willen de overgangen zo soepel mogelijk maken. Zo krijgen ze ook in de eenlingbox, als de biestperiode achter de rug is, al water en een beetje krachtvoer aangeboden. Dan is dat allemaal niet nieuw en ontwikkelt de pens ook voldoende om ruwvoer te verteren.”
In de kalverschuur zijn vier hokken ingedeeld voor de groepjes kalveren, waar ze ongeveer een maand in elk hok staan. In de eerste twee hokken staat de drinkautomaat en in deze hokken ligt stro. Geruime tijd na het spenen in het tweede hok gaan ze over naar het derde hok met deels stro en deels roosters. De laatste fase is een hok met alleen roosters en ligboxjes. Als ze zes maanden oud zijn, is het tijd voor verhuizing naar de stal. Verandering in rantsoen wordt niet tegelijk gedaan met een verplaatsing. Afbouwen van de melkgift en opbouwen van krachtvoer en ruwvoer vinden geleidelijk plaats.

Diarree is een veelvoorkomend probleem bij jonge kalveren. Goed en grondig schoonmaken is dus belangrijk. Van de eenlingboxen en biestverstekkers, alsook het overige materiaal waarmee wordt gewerkt en dat in aanraking komt met een kalf.
Kristy: “We hebben sinds enkele jaren verrijdbare eenlingboxen. Voor die tijd stonden de kalveren binnen in een ruimte die we niet goed konden schoonmaken. Deze aanpassing, waardoor we beter kunnen schoonmaken, heeft ervoor gezorgd dat we een stuk minder problemen hebben met diarree. We reinigen én ont smetten deze eenlingboxen goed en zetten ze dan in de zon. Op deze manier worden de meeste bacteriën en andere ziekteverwek kers gedood.”
Voor deze reportage zijn we benieuwd wat de resultaten van de Biestopnamecheck laten zien. Kristy: “We meten niet standaard de antistoffen in het bloed, in het verleden hebben we dat eens gedaan en was het prima. De brixwaarde is goed, we letten op de hygiëne dus ik verwacht dat de Biestopnamecheck die we nu mogen laten uitvoeren geen bijzonderheden laat zien.” En inderdaad: de uitslag van de Biestopnamecheck was goed.
Over het algemeen speelt diarree vaak al vroeg op; in de eerste paar weken in de eenlingboxen. “Door de kalveren goed in de gaten te houden, zie je het snel als er een probleem ontstaat. Dan kun je snel ingrijpen en naast melk bijvoorbeeld ook een elektrolytenmix inzetten. Dan krijgen de darmen rust en blijven de kalveren goed gehydrateerd. Diarree kan heel snel gaan en je wilt voorkomen dat het erge problemen geeft. Ik gebruik denk ik eens per twee maanden een sneltest om een kalf met diarree te testen op een eventuele aanwezige ziekteverwekker en zo meer gericht te kunnen behandelen of preventieve maatregelen toe te passen. Mest inleveren kan ook bij de dierenarts of GD, dan kan ook op coccidiose worden getest. Gelukkig hebben we het goed onder controle.”


De kalveren zien er gezond uit. Kristy houdt de groei goed in de gaten. “Ik meet zelf de borstomvang en hoogte. De kalveren zijn vroeg inseminatierijp, met twaalf maanden, maar wij houden der tien maanden aan voor het insemineren. Gezonde kalveren groeien harder. In de eerste maanden realiseren we groei door veel melk, goed ruwvoer en krachtvoer. Doordat we de overgangen klein hou den, zorgen we ervoor dat de kalveren geen groeidip krijgen na spe nen of verplaatsingen. De resultaten zijn goed, dat maakt het werk ook zo leuk. Het is mooi om te horen dat mensen vinden dat je het goed voor elkaar hebt. Het geeft ook voldoening, gezonde dieren om je heen. En gezonde kalveren groeien op tot gezonde melk koeien. Dat willen we graag zo houden en we blijven er dan ook zoveel tijd en aandacht in stoppen. Je verdient dat zo terug.”

In de kalverstal worden de overgangen zo klein mogelijk gehouden om stress te verminderen.
Om de overgangen klein te houden, krijgen de kalveren naast poedermelk ook water en voer aangeboden.
Het schoonmaken van de melkverstrekkers. Elk kalf heeft zijn eigen genummerde melkverstrekker.

“Gezonde kalveren groeien op tot gezonde melkkoeien.”

























































Het programma BVD-vrij route oorbiopten is handig voor bedrijven die het BVDonderzoek willen uitvoeren. Elk kalf wordt daarbij direct na geboorte onderzocht op virusdragerschap. Labonderzoek op oorbi opten is eenvoudig zelf digitaal aan te vra gen op VeeOnline. In dit artikel geeft Xander van onze klantenservice wat tips, zodat het insturen nog gemakkelijker gaat.

Xander: “Oorbiopten inschrijven kan eenvoudig via VeeOnline; onder het menu ‘Inschrijven’, staat ‘Nieuwe inschrijving’. VeeOnline maakt gebruik van de stallijst, zodat altijd de juiste levensnummers erin staan. Is het kalf al weg? Dan kan je het levensnummer invullen en op de donkerblauwe knop klikken. Dan wordt het levensnummer gevalideerd in I&R en kan ons lab zien om welk dier het gaat.
De inschrijving start met de knop ‘Toevoegen oorbiopten’. Inschrijven klaar? Na het ‘Verzenden’ kan ons laboratorium de
aanvraag zien. Daarna hoef je alleen nog de oorbiopten naar ons op te sturen.”
Waar vind ik mijn inschrijvingen en kan ik oorbiopten toevoegen?

Xander legt uit dat je ingeschreven monsters kunt inzien op VeeOnline, onder ‘Raadplegen inschrijvingen’. Zolang achter de inschrijving ‘Voorlopig geaccepteerd’ staat kun je nog oorbiopten toevoegen. Je heropent de inzending door op het groene pennetje in de module ‘Raadplegen inschrijvingen’ te klikken. Een nieuwe inschrijving is dan niet nodig, dat scheelt weer in de kosten! Staat de inschrijving op ‘Geaccepteerd’? Dat betekent dat ons lab alles goed heeft ontvangen. Een extra oorbiopt toevoegen is dan niet meer mogelijk.
In de GD-webshop log je in met je Z login, dezelfde als voor VeeOnline. Daar zijn oorbiopten en verzendmaterialen voor de oorbiopten te bestellen.
Met de VeeOnline-app kun je altijd en overal labuitslagen raadplegen. Daarnaast heb je via het archief de ‘historie’ van de dieren altijd bij de hand. Ontdek wat er voor jou in zit en download gratis de VeeOnline-app of neem contact op met onze klantenservice via 088 20 25 500.

Water is zowel voor mens als dier heel belangrijk. Het is belangrijk dat water altijd beschikbaar is en van een goede kwaliteit. Onze checklist kan helpen om de drinkwatervoorziening eens onder de loep te nemen. In deze Herkauwer aandacht voor het tweede checkpunt, over de waterbehandelingsinstallatie.
Om te zorgen dat een dier voldoende water opneemt en gezond blijft, is het belangrijk dat het water smakelijk, beschikbaar en van goede kwaliteit is. Maar wat is goed? GD heeft grenswaarden vastgesteld waaraan drinkwater voor dieren moet voldoen. Wateronderzoek geeft inzicht in de geschiktheid als drinkwater of eisen vanuit het certi ceringsprogramma. Vooral bij het gebruik van bronwater of oppervlaktewater is het zuiveren van het water nodig om het geschikt te maken als veedrinkwater. Hiervoor zijn veel verschillende systemen beschikbaar.
Het is belangrijk om te weten welk ltersysteem of waterbehandelingsinstallatie het meest passend is om het ‘ruwe’ bronwater te laten voldoen aan de grenswaarden voor veedrinkwater. Een watermonster bij de nieuwe bron kan het beste na twee tot vier weken wachten worden genomen, de bron moet eerst in evenwicht komen. Vervolgens moet de bron minimaal 24 uur hebben gepompt.

Regelmatig onderhoud van een waterbehandelingssysteem is nodig. Membranen van lters zijn gevoelig voor verontreiniging met bacteriën. Neem daarom na ingebruikname regelmatig een watermonster om te controleren of de waterbehandeling naar behoren functioneert.





Is er een onderhoudscontract en wordt dit nagekomen? Is lange tijd geen onderhoud gepleegd aan de installatie of heb je twijfels over de chemische kwaliteit van het bronwater? Neem dan een watermonster ná de lterinstallatie en vóórdat het water het drinkwatersysteem in gaat. Laat het monster analyseren op chemische parameters.


Blijkt uit de uitslag van het genomen watermonster op de drinkplek dat het bronwater chemisch niet in orde is? Loop dan de 9 checkpunten in de drinkwatervoorziening langs om de oorzaak van de afwijking te achterhalen. Het kan bijvoorbeeld nodig zijn om het water (anders) te behandelen of onderhoud te plegen aan de lterinstallatie. Bespreek de mogelijke vervolgstappen met degene die het ltersysteem of de waterbehandelingsinstallatie geplaatst heeft.
Dit zijn de belangrijkste checkpunten.
Wat is de kwaliteit van de herkomst van het water?
Is het water op de drinkplek schoon, helder en is het geurloos?
Dode leidingen
Vervuilde leidingen/biofilm
Doorhangende leidingen
Werkt de waterbehandelingsinstallatie naar behoren?
Zijn er koesignalen die kunnen wijzen op problemen met de drinkwatervoorziening?
Voldoet bronwater aan de door KKM of Foqus planet gestelde normen om melkwinningsapparatuur te reinigen of melk voor te koelen?
Wordt er iets toegevoegd aan het water?
Hoe is het waterleidingsysteem aangelegd?
Wat is de kwaliteit van het water in het buffervat?
Hoe is de watervoorziening bij het jongvee en de droge koeien?
Onvoldoende drinkbakken
• Waarom wateronderzoek doen?
Het is een goede controle om te onderzoeken of de waterbehandelingsinstallatie goed werkt.
• Welk onderzoek?
Er zijn diverse wateronderzoeken, zoals veedrinkwater chemisch onderzoek of de Drinkbakcheck. Op informatiepagina’s op onze website staat meer informatie.
• Wie mag een watermonster nemen?
Het watermonster kan worden genomen door de veehouder of dierenarts.
• Waar neem ik het monster?
Voor en na waterbehandelingsinstallatie. In de monsternameinstructie op onze website staat meer informatie over het nemen, inschrijven, verpakken en insturen van watermonsters naar GD.
• Hoe kan ik een monster insturen?
Vraag naar waterpotjes of een pakketje en bijbehorende inzendmaterialen bij de dierenartsenpraktijk. Of bestel het materiaal in de GD-webshop.



GD LOOPT VOOROP IN UIERGEZONDHEID VOOR GEZONDE UIERS EN MEER MELK
Tijdens de Rundvee & Mechanisatie Vakdagen (RMV) in Hardenberg en Gorinchem staat onze stand in het teken van jongvee. Een probleemloze opfok met focus op een goede ontwikkeling is voor een kalf essentieel voor een gezond, productief en vruchtbaar leven als melkkoe. We gaan hierover graag in gesprek.
Op onze stand zoomen we in op hygiëne en biestmanagement. Vraag jij je ook wel eens af hoe je de infectiedruk rondom de kal veren kan verlagen, zodat de kalveren nog beter opstarten? Het risico op ziekte is groter als een kalf wordt opgevangen in een vieze omgeving met een hoge infectiedruk. Goed biestmanage ment helpt om kalveren weerbaar te maken; schoon werken tij dens het opvangen en verstrekken van biest is daarbij essentieel.

Quiz: hygiëne en kalveren Hoeveel weet jij over hygiëne bij kalveren? En hoe schoon zijn de kalverboxen op jullie eigen bedrijf? Kom langs op onze stand,
Ook in 2021 stonden we op de RMV-beurs. Zien we je dit jaar bij onze stand?
test je kennis en ontvang een gratis pakket om de hygiëne van de kalverbox te laten testen. Dit onderzoek is één van de drie onderdelen van ons nieuwe product, de ‘Hygiënecheck Kalf’.
In Hardenberg, 25 tot en met 27 oktober, staan wij op een nieuwe plek. Je vindt ons op stand 164, dat is in hal 1 bij de ingang van het POAH-plein.
In Gorichem, 29 november tot en met 1 december, vind je ons op onze vaste plek: stand D122.
Als relatie van GD nodigen we je graag uit om de RMV te bezoeken!
Op het inzendformulier met anamnese ontbreekt vrijwel altijd informatie over de oorzaak van deze beschadigingen. Wel blijkt uit sectie duidelijk dat die zijn veroorzaakt door een behandeling. Voor de hand liggende oorzaken zijn het verkeerd inbrengen van een dren chslang, het gebruik van een stugge, rigide drenchslang al dan niet met een scherp uiteinde en fouten bij het gebruik van een pillenschieter. Op de foto is een voorbeeld van een derge lijke beschadiging achter in de keel te zien. De geopende bek van een melk koe met een beschadiging van het weefsel achter in de keel, die leidde tot een uitgebreide en ernstige ontste king van het weefsel rond het begin van de slokdarm. Het normale weefsel in de keel heeft een lichtrode kleur en heeft een glimmend oppervlak. Het beschadigde weefsel daarentegen heeft een afwijkende kleur en een dof oppervlak door de ontstekingsreactie.
Hier is ook te zien dat ruwvezel in het ontstekingsproces is ingesloten, waar schijnlijk door een drenchslang of pil lenschieter. Op de foto is een deel van een pincet te zien waarmee het ont stoken weefsel wordt aangewezen.
Bij het pathologisch onderzoek van gestorven melkvee zien we jaarlijks bij enkele runderen ernstige beschadigingen achter in de keel, die tot een dodelijke ontsteking in de keelstreek en rond de slokdarm en luchtpijp hebben geleid. Wat kunnen de oorzaken zijn en zijn deze te voorkomen?

Orale toediening van vocht, supplementen of medicijnen kan levensreddend zijn. Koeien hebben per dag rond de 40 liter water nodig voor onderhoud, plus ongeveer 4 liter per geproduceerde liter melk en bij hoge temperaturen (meer dan 20 graden Celsius) nog extra vocht om de lichaamstemperatuur te laten dalen. Totaal heeft een koe dus al snel 150 liter vocht per dag nodig.
Wanneer koeien ziek worden en minder drinken, kan het nodig zijn om een koe te drenchen om uitdroging te voorkomen. Ook is het oraal toedienen van supplementen of medicijnen in bolus sen, via pillenschieters of drenchapparaten, een praktische manier om een rund kort- of langdurig te behandelen of onder steunen. Veehouders en dierenartsen mogen orale toedieningen zelf toepassen. Indien het rund nog staat en kan slikken en het gewenste geneesmiddel of supplement voor orale toediening beschikbaar is, hoeft geen therapie via het bloedvat opgestart te worden. Dat scheelt in zorg, tijd en geld. Mits juist toegepast.
Juiste manier van toedienen Het is goed om te weten dat het rund slikt zodra een drench slang achter in de keel komt. Daarom hoeft bij het inbrengen van de slang geen kracht te worden gebruikt. Zodra het rund slikt kan de slang makkelijk worden doorgeschoven via de slokdarm naar de pens. Je kunt controleren of de slang de juiste weg vindt door te voelen in de hals (links boven luchtpijp), door te ruiken (geur pensinhoud) en door te luisteren naar het geluid door de slang (borrelend). Als de slang per ongeluk in de luchtpijp komt, gaat het rund hoesten. De slang moet dan worden teruggehaald om het inbrengen nogmaals te proberen.
• Goede mogelijkheden tot vastzetten van het rund. Rust, tijd, schone, complete en geschikte materialen. Het is handig voor mens en dier om het rund goed te xeren om de handeling rustig doch resoluut uit te voeren.
• Het is essentieel om te controleren of het materiaal waarmee wordt gewerkt nog soepel is, geen scherpe randjes heeft en geen gaten vertoont in de slang. Pillenschieters die alleen met veel kracht te hanteren zijn, kunnen voor ongecontroleerde of uitschietende bewegingen zorgen. Zo’n apparaat is aan vervanging toe. Ook zijn scherpe randjes aan het monddeel van het materiaal gevaarlijk. Deze randjes ontstaan meestal doordat het rund kauwt op het uiteinde van het instrument. Scherpe randjes kunnen zorgen voor beschadigingen in bek of keelstreek zonder dat dit in eerste instantie wordt opgemerkt. Let dus goed op de reactie van het dier.
• Het is bij de drenchslang van belang dat deze rigide genoeg is zodat de slang niet gauw kapot wordt gebeten, maar soepel genoeg is om makkelijk de slokdarm in te glijden.

Drenchslangen die lek zijn kunnen niet meer worden gebruikt vanwege een groot risico op verslikken.
Drenchen kan ook via een slang in de neus. Daarvoor is een slang met een kleinere diameter nodig. Deze slang moet een stuk soepeler zijn dan de slang die via de bek gaat. Ook moet de slang glad zijn. Aan het einde van een drenchsessie houd je de slang omhoog om leeg te blazen, zodat er geen vocht in de luchtpijp kan lopen bij het terugtrekken van de slang.

Kortom: gebruik goed materiaal. Een goede xatie en rustig handelen kan veel leed voorkomen.
Al sinds 2002 houdt Royal GD zich intensief bezig met de uitvoering van de diergezondheidsmonitoring in Nederland. Hiervoor werken wij nauw samen met onder andere de diersectoren, de zuivel, het ministerie van LNV, dierenartsen en veehouders. Deze rubriek verhaalt over bijzondere gevallen, speciaal onderzoek en opvallende resultaten die het werk van de monitoring oplevert. Samen werken we aan diergezondheid in het belang van dier, dierhouder en samenleving.
monitoring Auteur: Emma Strous, dierenartsEen goede xatie en rustig handelen kan veel leed voorkomen
Veehouders en dierenartsen vragen ons vaak om advies over salmonellatesten. Er zijn zoveel mogelijkheden dat soms door de bomen het bos niet te zien is. Daarom een kort overzicht: welke salmonellaonderzoeken heeft GD en wat kunnen rundveehouders ermee?
Op hoofdlijnen zijn er twee methoden van onderzoek: onderzoek op de salmonellabacterie zelf en onderzoek op antistoffen die het rund na infectie tegen salmonella vormt. Onderzoek op de salmonellabacterie kan al snel na infectie: de uitscheiding van salmonella in mest begint al na 12 tot 24 uur. Antistoffen tegen salmonella worden echter pas vanaf 10 tot 14 dagen na infectie meetbaar.
Voor onderzoek op de salmonellabacterie zelf gebruiken wij uiterst gevoelige kweekmethoden: de detectiegrens ligt op minder dan tien salmonellabacteriën per 25 gram mest. Het onderzoek wordt in verschillende combinaties uitgevoerd, afhankelijk van de behoefte aan snelheid (directe kweek is snel), gevoeligheid (kweek met voorophoping en ophoping is gevoelig) en het bepalen van het serotype en de gevoeligheid voor antibiotica (Tabel 1).
Voor onderzoek van monsters op antistoffen tegen salmonella gebruiken we twee technieken: ELISA’s en buisagglutinatietesten (Tabel 2). ELISA’s zijn voor de meeste toepassingen voor het aantonen van antistoffen geschikt; buisagglutinatietesten hebben alleen in enkele bijzondere situaties toegevoegde waarde. Belangrijk is dat de ELISA’s alleen antistoffen tegen de serogroepen B en D (zie kader ‘Salmonella’) kunnen detecteren.
Voor vier veel voorkomende situaties geven wij hieronder aan welk onderzoek het meest zinvol is:
Heeft een rund ziekteverschijnselen van salmonella? Dan is mestkweek (‘Salmonella kweek klinisch, typering’) vaak de eerste keus om de diagnose te stellen. Bij verwerpen kan de diagnose worden gesteld door sectie van de vrucht. Bloedonderzoek (‘Salmonella B/D LPS antistoffen-ELISA’) kan vanaf ongeveer twee weken na het begin van de verschijnselen worden uitgevoerd. Laat bloedmonsters van verwerpers ook onderzoeken op antistoffen tegen salmonella.
bij inzenden. *** Bijvoorbeeld mestputmonsters.
Tabel 1. Beschikbare testen voor het aantonen van salmonellabacteriën in monsters van rundveebedrijven.
Productnaam Monstertype Detecteert antistoffen tegen
Salmonella B/D LPS antistoffen ELISA
Individuele melk, tankmelk, bloed (serum)
in groep B en D
Salmonella Dublin H antistoffen BUA Bloed (serum) Serotype Dublin Bepaling van titer, daarmee is het mogelijk de concentratie antistoffen te vergelijken in twee gelijktijdig geteste monsters van één rund.Salmonella Typhimurium H antistoffen BUA Bloed (serum)
Typhimurium
Tabel 2. Beschikbare testen voor het aantonen van antistoffen tegen salmonellabacteriën.
De mestmonsters die binnenkomen bevatten vele soorten bacteriën en daar moet je salmonella in zien te vinden. Je zoekt dus naar een bepaalde kiem in een grote hoeveelheid andere kiemen. In sommige gevallen zijn de bacteriën waarnaar je op zoek bent uitgedroogd of beschadigd. Om de conditie van deze bacteriën te verbeteren krijgen ze eerst een oppepper in gebufferd peptonwater (BPW). Dit is een rijke bouillon waarin alle bacteriën groeien. Om ervoor te zorgen dat ze vermenigvuldigen gaan ze 16 tot 20 uur in een broedstoof bij 37ºC.
Na een nacht in de broedstoof start de selectieve ophoping. Van de voorophoping in BPW worden drie druppels met een gezamenlijk volume van 0.1 milliliter op een plaat met MSRV overgebracht; verspreid over de plaat. Na het incuberen van de plaat kan op basis van de kleur van het bacteriemateri-
aal en de aanwezigheid van een beweeglijkheidszone worden bepaald of salmonellabacteriën in het monster aanwezig zijn.
Salmonellabacteriën bewegen zich in het MSRVmedium vanuit het centrum van de entplaats (een druppel) naar buiten. Dit is zichtbaar als een grijswitte beweeglijkheidszone. Het medium bevat geen electieve bestanddelen (die zorgen ervoor dat de gewenste bacteriën een kenmerkend uiterlijk krijgen), maar heeft wel selectieve componenten, die de groei van de meeste ongewenste organismen remmen. Bovendien wordt de selectiviteit vergroot door een hoge (kritische) incubatietemperatuur van 41,5ºC.
De MSRV-plaat wordt zowel na 24 als na 48 uur incubatie beoordeeld. Als je na twee dagen geen beweeglijkheidszone in de agar ziet, is het onderzoek afgerond (uitslag: geen salmonella aangetoond). Als er wel sprake is van een beweeglijkheidszone, weet je nog niet zeker of het salmonella is. Salmonella is namelijk niet de enige bacterie die in het medium kan groeien en bewegen. Om de groei nader te onderzoeken wordt bacteriemateriaal van de rand van een beweeglijkheidszone
afgestreken op een XLD- en BGA-plaat. De platen worden overnacht geïncubeerd bij 37ºC.
BEOORDELING XLD EN BGA Salmonella vormt op XLDen BGA-platen roze kolonies; op XLD vaak met een zwart centrum. Bij de aanwezigheid van kenmerkende salmonellakolonies voert de analist een bevestiging uit.
Verdachte kolonies worden getest met een methode gebaseerd op massaspectrometrie, waarmee bacteriën snel en nauwkeurig kunnen worden geïdentificeerd. Met deze techniek wordt een massaspectrum gemaakt van een groep veelvoorkomende eiwitten van de bacterie. Deze eiwitten zijn zeer stabiel en gezamenlijk uniek voor de bacteriesoort; het massaspectrum is dan ook een soort ‘vingerafdruk’ van de bacterie. Deze ‘vingerafdruk’ wordt vervolgens in een database vergeleken met daarin opgeslagen massaspectra van bekende bacteriesoorten. Op basis van het aantal overeenkomstige pieken wordt een identicatiescore toegekend, waarmee de identiteit van de verdachte bacterie wordt bepaald.

Afhankelijk van het eerdere proces wordt op dag zes of dag zeven van het onderzoek de serotypering afgerond. Dit betekent dat dan ook het typeringsresultaat van de kweek bekend is.

Een klein deel van de besmette runderen blijft drager van de bacterie. Zij blijven de infectie verspreiden. Op langdurig besmette bedrijven draagt het afvoeren van salmonelladragers bij aan het beheersen van de infectie. Voor het opsporen van dragers wordt gebruik gemaakt van periodiek onderzoek op antistoffen (‘Salmonella B/D LPS antistoffen-ELISA’ in individuele melk of bloedmonsters). Herhaal het onderzoek elke zes maanden. De eerste keer dat antistoffen worden aangetoond is een mestkweek zinvol (‘Salmonella kweek opsporen drager’).
Salmonellose is een infectieziekte die wordt veroorzaakt door de salmonellabacterie. Het ziektebeeld varieert per bedrijf; koorts, diarree, verwerpen en sterfte komen veel voor bij vol wassen runderen. Bij kalveren zijn er vaak longontstekingen, diarree, groeivertraging, gewrichtsontstekingen of sterfte. De ziekte kan makkelijk worden overgedragen op mensen.
De salmonellabacterie wordt ingedeeld in een groot aantal (meer dan 2.500) types, ‘serotypes’ in het vakjargon. Deze serotypes worden weer samengevoegd tot ‘serogroepen’. Bij Nederlandse runderen worden de meeste besmettingen veroorzaakt door serogroep B (waaronder het serotype Salmonella Typhimurium) en serogroep D (waaronder het serotype Salmonella Dublin).
• Infectie op het bedrijf Op een snelle manier in beeld brengen of een salmonella-infectie op het bedrijf nog actief wordt verspreid? Combineer dan onderzoek van tankmelk (‘Salmonella B/D LPS antistoffenELISA’), bloedonderzoek van de vijf jongste kalveren van tenminste 90 dagen, die tenminste 70 dagen op het bedrijf zijn (‘Salmonella B/D LPS antistoffen-ELISA’) en mestputonderzoek (‘Salmonella kweek en typering omgevingsmonster’).
• Afwezigheid van een salmonella-infectie Wilt u laten zien dat uw bedrijf een hoge kans op afwezigheid van een salmonellabesmetting heeft, bijvoorbeeld voor de ver koop van runderen voor het leven? Dan is een status ‘SalmonellaOnverdacht’ waardevol. Voor het behalen en bewaken van deze status wordt gebruikgemaakt van periodiek onderzoek, van bewa king op de aanvoer van runderen en van bewaking op positieve uitslagen van uitgevoerd onderzoek. Het periodieke onderzoek bestaat op melkveebedrijven uit tankmelkonderzoek (‘Salmonella B/D LPS antistoffen-ELISA’) en op overige bedrijven uit steek proefbloedonderzoek (‘Salmonella B/D LPS antistoffen-ELISA’).
Door de salmonellasituatie op het bedrijf te monitoren met een salmonellaprogramma is snel ingrijpen mogelijk.
LEES HIER MEER INFORMATIE






























De meeste kuiluitslagen van de voorjaarskuilen zijn bekend. We hoopten dat vele uitslagen zouden volgen, maar de droogte zorgde voor een grote uitdaging in de voederwinning dit jaar. Op sommige pekken was het erg droog waardoor er geen of weinig gras kon worden gemaaid. Hoe zit het met mineralen en spoorelementen in deze kuilen?
Bij de kuiluitslagen gaat veel aandacht uit naar de voederwaarde-analyse (energie, eiwit, structuur en verteringkarakteristieken). Vaak vergeten, maar minstens zo belangrijk, is de analyse van de mineralen en spoorelementen.
Als er geen gegevens bekend zijn, kan geen rantsoenberekening worden gemaakt van de mineralen en spoorelementen. De keuze van het (standaard) mineralenmengsel en de hoeveelheid is in een dergelijke situatie een blinde gok. Historische gegevens kunnen enigszins richting geven, maar geven nooit een accuraat beeld. Het bemestingsniveau en de weersomstandigheden bij de teelt van gewas beïnvloeden de mineralensamenstelling van het gewas en deze verschilt van jaar tot jaar.
Als we alleen al het afgelopen groei-jaar vergelijken met dit jaar, dan is dat een wereld van verschil. Ook de groeiperiode binnen het groeiseizoen beïnvloedt de samenstelling. De mate van bodemactiviteit (bodemtemperatuur), het op gang komen van bodemmineralisatie, de vochttoestand en de zuurtegraad vertalen zich naar verschillende gehalten over de jaren heen. Het is ook zeker niet ondenkbaar dat de botanische samenstelling van invloed is op de mineralen en spoorelementen.





Er zijn mineralen die elkaar kunnen verdringen, deze interactie zorgt ervoor dat de opname van andere mineralen wordt geremd. Bekende interacties zijn zwavel, molybdeen en koper. Maar ook kalium versus magnesium. Andere interacties zijn bekend, alleen te moeilijk of niet te kwanti ceren in een berekening. Daarom is aanvullend onderzoek ter indicatie of controle van de actuele voorziening van meerwaarde, zowel vooraf als naderhand. Een bijzonder aandachtspunt is dat enkele spoorelementen een veiligheidsmarge kennen in de normstelling. Zo kent koper een veiligheidsfactor van 1,5. Een voorziening groter dan 100 procent ten opzichte van de norm is dan ook niet noodzakelijk.


vitaminen en mineralen
Een tekort aan spoorelementen kan onder andere de diergezondheid, vruchtbaarheid, klauwgezondheid en het energiemetabolisme negatief beïnvloeden. Overmaten kunnen eveneens een negatieve invloed uitoefenen, onder andere door stapeling in de lever of door verdringing. Bovendien vormt het tegelijkertijd een onnodige kostenpost. Voor mineralenonderzoek geldt dan ook: kosten gaan voor de baten uit! Iets om als veehouder over na te denken voor de kuilbemonsteringen die nog komen.

Erwin de Heer, dierenarts en Sietske Haarman, specialist buitendienst
Bespreek je de mineralenvoorziening met de dierenarts? Door kennis en waarnemingen samen te brengen, heb je een goed onderbouwde basis voor het bepalen van een gezamenlijke en eenduidige (voer)strategie. Hij of zij kent het bedrijf. De fysiologische achtergronden van bedrijfs- of gezondheidsproblemen zijn waardevolle aanvullingen bij het maken van keuzes in de rantsoenen en mineralenvoorziening. We zien dat dierenartsen en veevoervoorlichters regelmatig samenwerken en elkaar goed aanvullen om veehouders optimaal te ondersteunen. Naast de voeranalyses en rantsoenberekening, is de Mineralencheck een zeer waardevolle aanvulling om te monitoren wat de opname van mineralen op koppelniveau is.
Ruim een kwart van de Nederlandse melkveehouders neemt deel aan de Mineralencheck. Die geeft via tankmelk inzicht in de jodium-, seleniumzink-, koper- en molybdeenvoorziening en de fosforuitscheiding van melkvee. In de uitslagen zien we een jaarlijkse trend; elke zomer is er een dip in de gemeten hoeveelheden spoorelementen. Deze zomerdip is dit jaar vergelijkbaar met eerdere jaren. Wat wel opvalt is dat de dip dit jaar eerder begon. We zagen in de tankmelkuitslagen van mei al meer bedrijven in de categorie ‘laag/normaal’ voor meerdere spoorelementen dan andere jaren. Dit kan mogelijk te maken hebben gehad met een andere groeiseizoen, maar ook met andere trends in de bedrijfsvoering zoals het eerder starten met weiden.
De GD-relatiebeheerders geven advies over uw bedrijfssitua tieen de ondersteuning die wij u kunnen bieden. Bijvoorbeeld als u een vraag heeft over een onverwachte verandering van de gezondheidsstatus van uw koeien. Of als u meer informatie wilt over diergezondheid (zoals BVD, parasieten, klauwen uiergezondheid of drinkwater) en wilt weten welke GD-programma’s op uw bedrijf van meerwaarde kunnen zijn.
Relatiebeheerder Andreas Lameris sprak onlangs een melkveehoudster. Zij vond dat het tankcelgetal van haar melkveebedrijf de afgelopen zomer structureel te hoog was, maar ze kon daar geen directe verklaring voor vinden. “Mijn advies was om te beginnen met het verkrijgen van meer inzicht in de aanwezige mastitisverwekkers middels het programma Mastitis Tankmelk. Dan wordt laagdrempelig en frequent onderzocht welke masti-

tiskiemen, en in welke mate, aanwezig zijn op het bedrijf. Met die informatie kan zij eerder en beter inspelen op de aanwezige risicofactoren behorende bij de aangetroffen kiemen.”
Andreas: “Na het eerste onderzoek heeft één van mijn collega’s die is gespecialiseerd in uiergezondheid contact opgenomen om de uitslag toe te lichten. Daarnaast is via VeeOnline het Dashboard Uiergezondheid te raadplegen, met veel achtergrondinformatie bij de uitslagen. Ook de UGA-wijzer gaf haar uiteindelijk genoeg aanknopingspunten om het tankcelgetal weer op een meer acceptabel niveau te krijgen en vervelende verassingen in de toekomst te helpen voorkomen.”






































het getal
Brucella-monitoringsbloedonderzoek van verwerpers is van essentieel belang voor het bedrijf en de export van producten.
Brucella is een ziekte die nog steeds binnen Europa aanwezig is en wereldwijd voor mens en dier een groot probleem is. Nederland heeft sinds 1999 de officiële status brucella-vrij. Deze vrij-status is nodig voor onbelemmerde export van producten en dieren. Een status die alleen wordt bewaakt door bloedonderzoek van verwerpers. Alle verwerpers die drachtig waren tussen 100 en 260 dagen dienen binnen 7 dagen na verwerpen onderzocht te
worden. Voor visite, bloedafname en brucella-onderzoek worden geen kosten in rekening gebracht bij de veehouder.
Brucella verspreidt zich via dieren en sperma. Zeker bij jongvee is een eventuele besmetting niet meteen in het bloed te herkennen. De ziekte wordt dan pas ontdekt als een rund spontaan aborteert. Juist op dat moment is de verspreiding van de besmettelijke bacterie het hoogst. Import van dieren en sperma van een niet gecertificeerd KI-station zijn risicofactoren die brucella opnieuw in Nederland kunnen introduceren.

“Op basis van ingezonden verwerpersbloed zien we dat momenteel de aandacht om bloed in te zenden verslapt. Doordat de enige monitoring plaatsvindt via het verwerpersonderzoek is dit onder zoek van essentieel belang. Want hoe eerder het wordt ontdekt, hoe minder verspreiding optreedt.
Het zogenoemde ‘verwerpersbloedje’ biedt je ook de kans te zoeken naar andere infectieuze oorzaken van verwerpen. Voor veehouders die deelnemen aan onze programma’s voor IBR, leptospirose,
neospora en salmonella wordt het bloedmonster ook automatisch en zonder extra kosten onderzocht op de ziekte waarop het programma betrekking heeft.
Daarnaast kunt u altijd extra onderzoek aanvragen, zoals BVD, tegen betaling van die onderzoekskosten.
Ook waterbuffels kunnen besmet raken door brucella. Hoewel bloedafname bij waterbuffels lastiger is dan bij rundvee en het niet altijd te zien is welk dier verworpen heeft, dient ook bij waterbuffels verwerpersbloed te worden ingezonden.”
DAGEN IS DE TERMIJN WAARBINNEN HET BLOEDONDERZOEK VAN VERWERPERS MOET ZIJN UITGEVOERD
Els Uijterlinde is samen met haar man Gerard de vierde generatie sinds 1905 die Erve Mentink voortzet. Het bedrijf telt 196 melkkoeien en vijftig stuks jongvee tot een half jaar. Daarna vertrekt het jongvee naar het bedrijf van haar neef, met wie een Veterinaire Eenheid wordt gevormd. “Ik ben een echt buitenmens, houd van het werken met vee en wil altijd weten hoe iets beter of ef ciënter kan. Tussen de dieren ben ik gelukkig.”
Els werkte eerst bij een diervoederbedrijf. Na een aantal jaren besloot ze dat ze toch het familiebedrijf wilde voortzetten. Haar opgedane kennis zet ze graag in de praktijk in. “Je wilt graag dat de koeien probleemloos oud worden.”
Uier- en klauwgezondheid onder controle Enkele jaren geleden was Staphylococcus aureus een probleem. “We hebben bacteriologisch onderzoek ingezet bij GD en de koeien zijn behandeld of afgevoerd. Je moet er bovenop zitten. Als je het laat sluimeren dan raken veel andere koeien geïnfecteerd. Ook kenden we Mortellaro-problemen, die nu weer onder controle zijn. Wekelijks een voetbad en we bekappen in de droogstand en bij problemen. Afgelopen voorjaar zagen we wel meer wittelijn-defecten die maar moeizaam genezen. De eerste snede is vorig jaar verregend, ik denk dat het probleem daar zit. Gegevens van Klauwgezondheid Tankmelk geven een mooi inzicht waar klauwproblemen door kunnen komen. Daar kwam gelukkig uit dat de infectiedruk met Mortellaro nu laag is. De mineralentoestand gebruiken we voor het optimaliseren van de voedermineralen”, legt Els uit.
Aan de slag met thema’s Op het bedrijf werken ze met thema’s om daaraan te werken. “We vragen ons bij alles af, wat past bij ons bedrijf en bij onze situatie? Hoe kan het anders, beter? De koeien lopen op droge zandgrond. Ik denk dat het gebruikmaken van kruidenrijk grasland, met daarin meer mineralen, gezonder is voor de dieren. We merkten op een gegeven moment dat de opstart na afkalven moeizamer ging. We hebben de droge koeien een uitloop met beperkte weidegang aangeboden. Daarna ging de opstart beter.”





Op Erve Mentink delen ze graag kennis met andere bedrijven. De wetenschap wordt verbonden met de praktijk in verschillende onderzoeksprojecten op het bedrijf. Els: “Als je bedrijf en de manier van werken bij jou past, dan houd je het vol en is het duurzaam. Jij moet er energie van krijgen. Ook binnen de huidige onzekerheid wil ik kansen blijven zoeken door kennis in te zetten. Door met collega’s te praten, kom je erachter hoe zij iets aanpakken. Je weet niet alles en samen kun je veel leren!”

Interesse in een bedrijfsbezoek, voor bijvoorbeeld een studiegroep? Op www.ervementink.nl staat meer informatie.










9, 7400 AA Deventer, T. 088 20 25 500, www.gddiergezondheid.nl,


